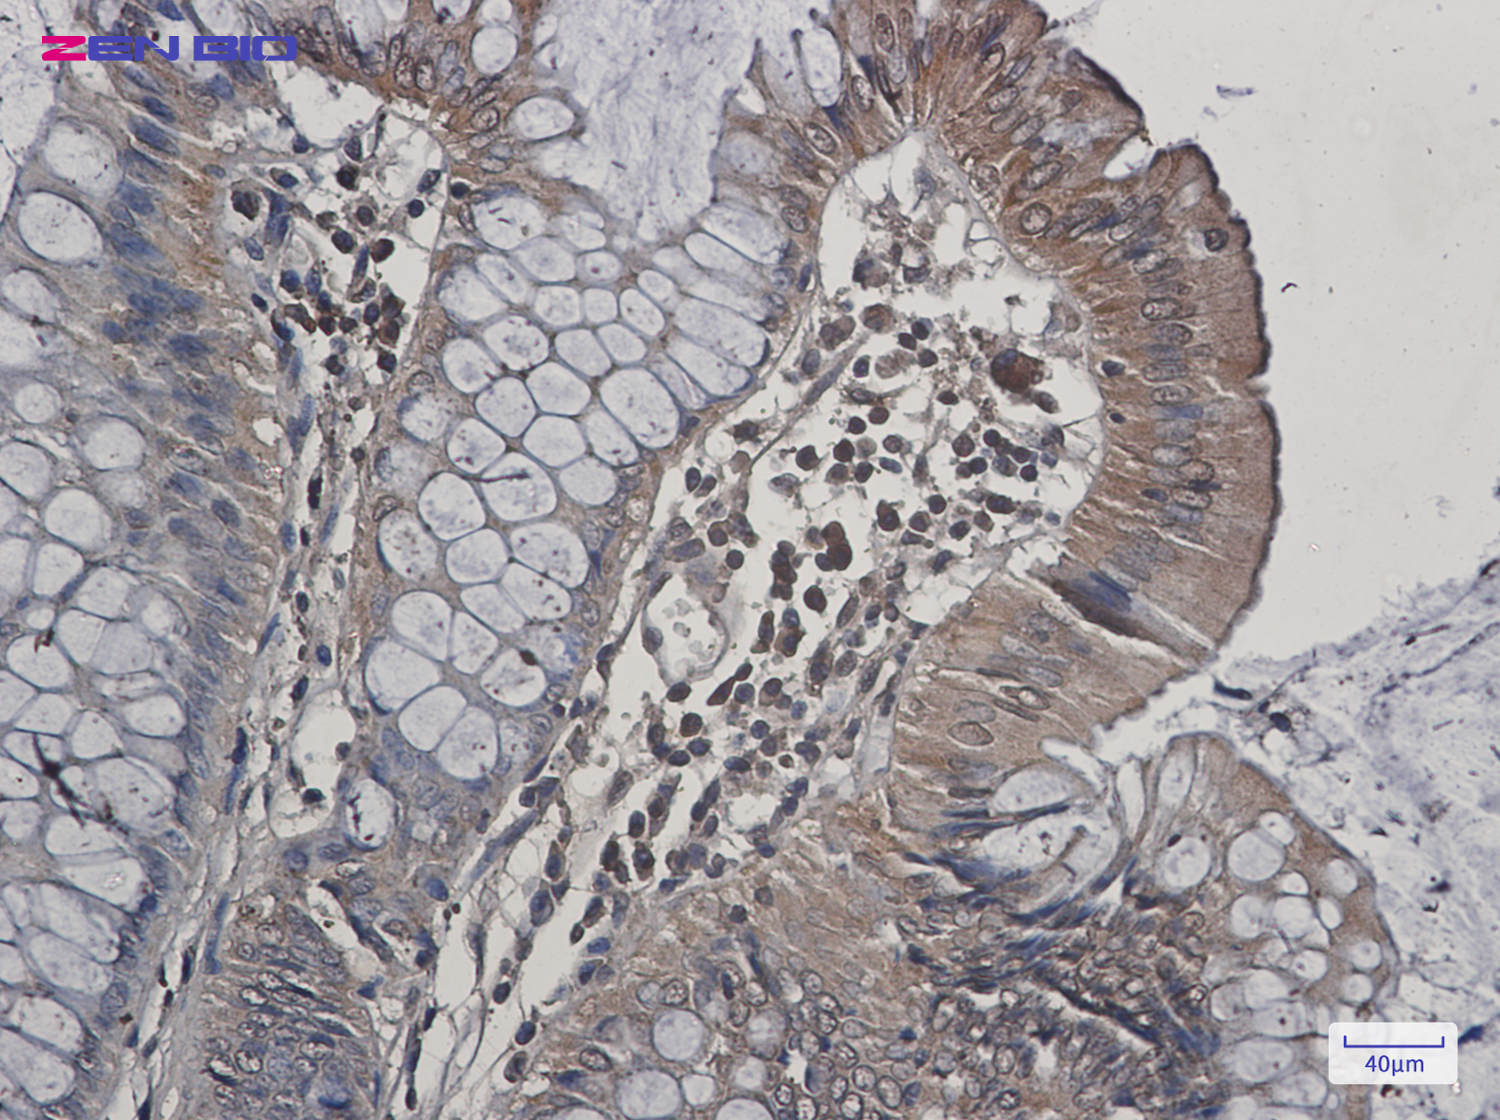
Immunohistochemistry of JNK2 in paraffin-embedded Human colon cancer tissue using JNK2 Rabbit pAb at dilution 1/20

-
Product Name
Anti-JNK2 Rabbit antibody
- Documents
-
Description
JNK2 Rabbit polyclonal antibody
-
Tested applications
WB, IHC-P, FC, IP
-
Species reactivity
Human, Mouse, Rat
-
Alternative names
JNK2; SAPK; p54a; JNK2A; JNK2B; PRKM9; JNK-55; SAPK1a; JNK2BETA; p54aSAPK; JNK2ALPHA antibody
-
Isotype
Rabbit IgG
-
Preparation
Antigen: A synthetic peptide of human JNK2
-
Clonality
Polyclonal
-
Formulation
Supplied in 50nM Tris-Glycine(pH 7.4), 0.15M Nacl, 40%Glycerol, 0.01% sodium azide and 0.05% BSA.
-
Storage instructions
Store at -20°C. Stable for 12 months from date of receipt.
-
Applications
WB: 1/1000-1/2000
IHC: 1/20-1/50
FC: 1/20
IP: 1/20
-
Validations

Western blot detection of JNK2 in C6,3T3 cell lysates using JNK2 Rabbit pAb(1:1000 diluted).Predicted band size:48kDa.Observed band size:54kDa.
Immunohistochemistry of JNK2 in paraffin-embedded Human colon cancer tissue using JNK2 Rabbit pAb at dilution 1/20
-
Background
Swiss-Prot Acc.P45984.Serine/threonine-protein kinase involved in various processes such as cell proliferation, differentiation, migration, transformation and programmed cell death. Extracellular stimuli such as proinflammatory cytokines or physical stress stimulate the stress-activated protein kinase/c-Jun N-terminal kinase (SAP/JNK) signaling pathway. In this cascade, two dual specificity kinases MAP2K4/MKK4 and MAP2K7/MKK7 phosphorylate and activate MAPK9/JNK2. In turn, MAPK9/JNK2 phosphorylates a number of transcription factors, primarily components of AP-1 such as JUN and ATF2 and thus regulates AP-1 transcriptional activity. In response to oxidative or ribotoxic stresses, inhibits rRNA synthesis by phosphorylating and inactivating the RNA polymerase 1-specific transcription initiation factor RRN3. Promotes stressed cell apoptosis by phosphorylating key regulatory factors including TP53 and YAP1. In T-cells, MAPK8 and MAPK9 are required for polarized differentiation of T-helper cells into Th1 cells. Upon T-cell receptor (TCR) stimulation, is activated by CARMA1, BCL10, MAP2K7 and MAP3K7/TAK1 to regulate JUN protein levels. Plays an important role in the osmotic stress-induced epithelial tight-junctions disruption. When activated, promotes beta-catenin/CTNNB1 degradation and inhibits the canonical Wnt signaling pathway. Participates also in neurite growth in spiral ganglion neurons. Phosphorylates the CLOCK-ARNTL/BMAL1 heterodimer and plays a role in the regulation of the circadian clock (PubMed:22441692). Phosphorylates POU5F1, which results in the inhibition of POU5F1's transcriptional activity and enhances its proteosomal degradation .
Related Products / Services
Please note: All products are "FOR RESEARCH USE ONLY AND ARE NOT INTENDED FOR DIAGNOSTIC OR THERAPEUTIC USE"
